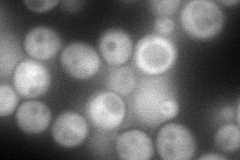
YER099C
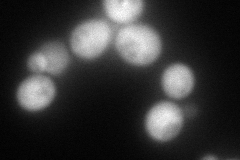
YER099C
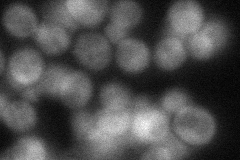
YER099C
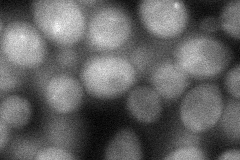
YER099C
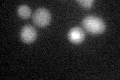
YER099C

View description
5-phospho-ribosyl-1(alpha)-pyrophosphate synthetase, synthesizes PRPP, which is required for nucleotide, histidine, and tryptophan biosynthesis; one of five related enzymes, which are active as heteromultimeric complexes
Localization:
Intensity:
Fold change:
Significance:
-
C’ GFP library in SD

below threshold14.79 -
N' NOP1pr-GFP in SD
cytosol121.94 -
N' TEF2pr-mCherry in SD
cytosol175.99 -
N' NATIVEpr-GFP in SD
cytosol37.2691 -
N' TEF2pr-VC and Cyto-VN in SD
cytosol41.0847 -
C’ GFP library in SD+DTT
cytosolN/AN/ANo -
C’ GFP library in SD+H2O2

cytosolN/AN/ANo -
C’ GFP library in Starvation Media

technical problem0N/AYes -
C’ GFP library on the background of Pup2-DaMP

below threshold -
C’ GFP library on the background of CCT mutant

below thresholdN/AN/ANo
